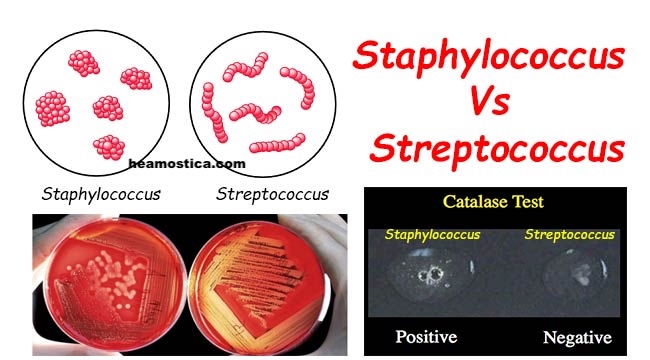
افتراق استافیلوکوک از استرپتوکوک

افتراق استافیلوکوک از استرپتوکوک: راهنمای جامع، عملی و بالینی برای کارشناسان آزمایشگاه میکروبیولوژی
افتراق استافیلوکوک از استرپتوکوک یکی از مهمترین مهارتهای کارشناسان میکروبیولوژی در آزمایشگاه است، زیرا هر دو گروه کوکسی گرممثبت میتوانند عفونتهای بالینی مشابهی ایجاد کنند اما الگوی بیماریزایی، مقاومت آنتیبیوتیکی و درمان کاملاً متفاوتی دارند. در این راهنمای جامع، تمام جنبههای عملی، میکروسکوپی، بیوشیمیایی، مولکولی، کشت، اپیدمیولوژی و خطاهای رایج در افتراق استافیلوکوک (Staphylococcus) از استرپتوکوک (Streptococcus) را بهصورت مرحلهبهمرحله و کاربردی بررسی میکنیم.
جهت عضویت در کانال آموزشی در تلگرام به لینک زیر مراجعه کنید:
https://t.me/hematology_education
فهرست مطالب
- مقدمه: اهمیت افتراق استافیلوکوک از استرپتوکوک در آزمایشگاه
- ویژگیهای مورفولوژیک و میکروسکوپی در افتراق استافیلوکوک از استرپتوکوک
- تستهای بیوشیمیایی و آنزیمی اولیه: کاتالاز، کوآگولاز و همولیز
- تستهای پیشرفته و مولکولی در افتراق استافیلوکوک از استرپتوکوک
- روشهای کشت و محیطهای انتخابی برای استافیلوکوک و استرپتوکوک
- جنبههای بالینی و اپیدمیولوژیک و عفونتهای بیمارستانی
- چالشها و خطاهای رایج در افتراق استافیلوکوک از استرپتوکوک
- جدولهای افتراقی آزمایشگاهی و بالینی استافیلوکوک و استرپتوکوک
- نتیجهگیری: الگوریتم عملی افتراق استافیلوکوک از استرپتوکوک
- سوالات رایج درباره افتراق استافیلوکوک از استرپتوکوک (FAQ)
- منابع معتبر برای مطالعه بیشتر
برای مرور اصول و روش کار رنگآمیزی گرم (Gram staining) که پایه افتراق کوکسیهای گرممثبت است، میتوانید این مقاله را در هموستیکا ببینید:
روش کار رنگ آمیزی گرم: اصول، روش و کاربردها
مقدمه: اهمیت افتراق استافیلوکوک از استرپتوکوک در میکروبیولوژی تشخیصی
تمایز دقیق بین دو جنس مهمِ کوکسیهای گرممثبت یعنی استافیلوکوکها (Staphylococcus) و استرپتوکوکها (Streptococcus) از بنیادیترین مهارتها در یک آزمایشگاه میکروبیولوژی تشخیصی است. در نگاه اول، هر دو گروه در رنگآمیزی گرم به صورت کوکسیهای بنفشرنگ دیده میشوند و اگر تنها به همین مشاهده اکتفا شود، خطر اشتباه تشخیصی، درمان نامناسب و در نتیجه افزایش عوارض برای بیمار بهطور جدی وجود دارد.
استافیلوکوکها و استرپتوکوکها از نظر محل کلونیزاسیون در بدن، طیف بیماریها، الگوهای مقاومت آنتیبیوتیکی، و اهمیت اپیدمیولوژیک تفاوتهای چشمگیری دارند. برای مثال، استافیلوکوک اورئوس (Staphylococcus aureus) به عنوان یک پاتوژن فرصتطلب مهم، در عفونتهای پوستی و بافت نرم، آبسهها، اندوکاردیت عفونی، عفونت زخمهای جراحی و پنومونی بیمارستانی نقش کلیدی دارد و ظهور سویههای مقاوم به متیسیلین (MRSA: Methicillin-Resistant Staphylococcus aureus) آن را به یک چالش جدی در کنترل عفونتهای بیمارستانی تبدیل کرده است. در مقابل، استرپتوکوک پیوژنز (Streptococcus pyogenes، گروه A) عامل اصلی فارنژیت چرکی، تب مخملک، سلولیت و در ادامه عوارض پسعفونی مانند تب روماتیسمی و گلومرولونفریت حاد پساسترپتوکوکی است. استرپتوکوک گروه B (Streptococcus agalactiae) نیز از عوامل اصلی سپسیس و مننژیت نوزادی به شمار میرود.
از منظر آزمایشگاهی، روشهای مختلفی برای افتراق استافیلوکوک از استرپتوکوک وجود دارد که شامل بررسیهای میکروسکوپی، تستهای بیوشیمیایی و آنزیمی، الگوی رشد در محیطهای کشت انتخابی و افتراقی، تستهای سرولوژیک و در نهایت روشهای مولکولی و مبتنی بر طیفسنجی جرمی است. یک کارشناس آزمایشگاه باید بتواند این روشها را در قالب یک الگوریتم منطقی و گامبهگام به کار بگیرد؛ یعنی از مشاهدات ابتدایی مانند آرایش سلولی در گسترش مستقیم و رنگآمیزی گرم، به سمت تستهای سریع ابتدایی مثل کاتالاز و کوآگولاز، و در صورت نیاز به روشهای تکمیلی مانند گروهبندی لنسفیلد، شناسایی با MALDI-TOF یا PCR حرکت کند.
علاوهبراین، شناخت منابع خطا و محدودیتهای هر تست (مثلاً مثبت کاذب کاتالاز به دلیل استفاده از کلنی روی آگار خون، یا اشتباه گرفتن استرپتوکوک پنومونیه با استافیلوکوکهای خوشهای در گسترشهای نامناسب) برای جلوگیری از گزارش غلط الزامی است. در این مقاله تلاش شده است که با حفظ ساختار منظم، هر بخش بهطور مفصل از دید عملی، علمی و بالینی بررسی شود تا این متن بتواند به عنوان یک مرجع کاربردی در کنار کتابهای مرجع کلاسیک مانند Bailey & Scott’s Diagnostic Microbiology در آزمایشگاه مورد استفاده قرار گیرد.
افتراق استافیلوکوک از استرپتوکوک
عفونتهای بیمارستانی به عفونتهایی گفته میشود که در زمان پذیرش بیمار در بیمارستان یا مرکز درمانی وجود نداشتهاند و معمولاً حداقل ۴۸ ساعت پس از بستری ظاهر میشوند، یا پس از ترخیص و در ارتباط با مداخلات درمانی و مراقبتی ایجاد میگردند. عوامل شایعی مانند استافیلوکوک اورئوس (بهویژه MRSA) و برخی استرپتوکوکها میتوانند در ایجاد این عفونتها نقش داشته باشند و افتراق صحیح آنها برای کنترل عفونت و انتخاب درمان مناسب حیاتی است.
برای آشنایی بیشتر با اصول کلی کنترل کیفی در میکروبشناسی (Microbiology Quality Control) و ارتباط آن با صحت نتایج در افتراق استافیلوکوک از استرپتوکوک، این مطلب را در هموستیکا مطالعه کنید:
کنترل کیفی میکروب شناسی: اصول، روشها و استانداردهای عملکردی
ویژگیهای مورفولوژیک و میکروسکوپی در افتراق استافیلوکوک از استرپتوکوک
اولین نقطه تماس کارشناس با یک میکروارگانیسم جدید، معمولاً مشاهده کلنی روی محیط کشت و سپس رنگآمیزی گرم (Gram stain) است. هرچند امروزه روشهای خودکار و مولکولی گسترش یافتهاند، اما هنوز هم در اغلب آزمایشگاهها، نگاه دقیق به مورفولوژی کلنی و آرایش سلولی زیر میکروسکوپ مهمترین گام در افتراق اولیه است.
در رنگآمیزی گرم، هر دو جنس استافیلوکوک و استرپتوکوک به صورت کوکسیهای گرممثبت ظاهر میشوند. این یعنی پس از انجام صحیح رنگآمیزی (کریستال ویوله، ید، رنگبر و سافرنین)، باکتریها به رنگ بنفش یا بنفش تیره مشاهده میشوند. تفاوت اصلی نه در رنگ، بلکه در نحوه تقسیم سلولی و آرایش نهایی آنها است. استافیلوکوکها در چند صفحه تقسیم میشوند و در نتیجه سلولها به صورت خوشهای و شبیه به خوشه انگور کنار هم قرار میگیرند. این آرایش خوشهای، بهویژه در گسترشهایی که از کلنی جوان و تازه تهیه شده باشد، بسیار مشخص است و یک نشانه مهم برای تشخیص است. در مقابل، استرپتوکوکها معمولاً در یک صفحه تقسیم میشوند و در نتیجه به صورت زنجیرهای از کوکسیها یا دیپلوکوک (دو تا دو تا) دیده میشوند. در استرپتوکوک پنومونیه (Streptococcus pneumoniae)، اغلب دیپلوکوکهای لانستشکل (Lancet-shaped) مشاهده میشوند که تشخیص آن را از دیگر استرپتوکوکها تسهیل میکند.
با این حال، آرایش سلولی همواره به این وضوح نیست. اگر از کلنیهای خیلی قدیمی، یا محیطهای کشت نامناسب، یا گسترشهای خیلی ضخیم استفاده شود، ممکن است خوشهها بهصورت نامنظم و نامشخص دیده شوند و زنجیرهها نیز بهخوبی قابل تشخیص نباشند. در این شرایط، تکیه صرف بر مورفولوژی میکروسکوپی خطرناک است و باید آن را در کنار تستهای بیوشیمیایی قرار داد. بنابراین، توصیه میشود برای رنگآمیزی گرم، از کلنی ۱۸ تا ۲۴ ساعته روی محیطهای استاندارد (مانند آگار خون یا آگار مولر–هینتون بدون آنتیبیوتیک) استفاده شود.
از نظر مورفولوژی کلنی نیز تفاوتهایی وجود دارد. استافیلوکوکها روی آگار خون یا آگار نوترینت معمولاً کلنیهای گرد، برجسته، براق و گاهی پیگمانته (مثلاً S. aureus با کلنیهای زرد – طلایی) ایجاد میکنند. بسیاری از استافیلوکوکها قادر به رشد روی محیطهای با غلظت بالای نمک (۷٫۵٪ NaCl) هستند و همین ویژگی در مانیتول سالت آگار (Mannitol Salt Agar) برای انتخاب آنها استفاده میشود. در مقابل، استرپتوکوکها اغلب رشد کندتر و کلنیهای کوچکتر و ماتتر دارند و نمایش الگوی همولیز روی آگار خون در مورد آنها اهمیت ویژهای دارد. بهعنوان مثال، S. pyogenes کلنیهای کوچک با بتاهمولیز واضح اطراف خود ایجاد میکند، در حالی که S. pneumoniae معمولاً کلنیهای فرورفته با آلفاهمولیز (سبز شدن هموگلوبین) تولید میکند.
در گسترشهای مستقیم از نمونههای بالینی مانند خون، مایع مغزی–نخاعی یا ترشحات، تشخیص اینکه کوکسیهای گرممثبت مشاهدهشده به کدام جنس تعلق دارند، همیشه ممکن نیست؛ زیرا آرایش سلولی در نمونههای مستقیم ممکن است به علت حضور لکوسیتها، فیبرین و سایر عناصر، مختل شود. با این وجود، هر چه مقدار و کیفیت نمونه بهتر باشد و تجربه کارشناس بیشتر، احتمال تشخیص اولیه بالاتر است. در هر صورت، تشخیص نهایی باید بر پایه ترکیب اطلاعات میکروسکوپی، الگوی رشد و نتایج تستهای بیوشیمیایی انجام شود، نه صرفاً بر اساس ظاهر سلولی.
اگر نیاز دارید اصول عملی رنگآمیزی گرم (Gram stain) را قبل از افتراق استافیلوکوک از استرپتوکوک مرور کنید، پیشنهاد میشود این مقاله را ببینید:
روش کار رنگ آمیزی گرم: اصول، روش و کاربردها
تستهای بیوشیمیایی و آنزیمی اولیه در افتراق استافیلوکوک از استرپتوکوک
بعد از مرحله مشاهده میکروسکوپی، در اغلب آزمایشگاهها اولین تست بیوشیمیایی برای افتراق بین استافیلوکوک و استرپتوکوک، تست کاتالاز (Catalase test) است. این تست ساده، سریع و ارزان، اگر بهدرستی انجام و تفسیر شود، در چند ثانیه میتواند مسیر تشخیصی را مشخص کند.
تست کاتالاز در افتراق استافیلوکوک از استرپتوکوک
آنزیم کاتالاز، پراکسید هیدروژن (H2O2) را به آب و اکسیژن تجزیه میکند. برای انجام تست، مقدار کمی از کلنی باکتری را با لوپ یا چوبک روی لام شیشهای قرار میدهیم و یک قطره H2O2 (معمولاً ۳٪) روی آن میچکانیم. اگر آنزیم کاتالاز وجود داشته باشد، تولید سریع حبابهای ریز اکسیژن مشاهده میشود و تست مثبت است.
استافیلوکوکها بهطور تیپیک کاتالاز مثبت هستند و استرپتوکوکها کاتالاز منفی. بنابراین، اگر با یک کوکسی گرممثبت روبهرو باشیم که در تست کاتالاز مثبت است، به سمت استافیلوکوک (یا سایر کوکسیهای گرممثبت کاتالاز مثبت مثل میکروکوکها) هدایت میشویم، و اگر منفی باشد، احتمال استرپتوکوک یا انتروکوک مدنظر قرار میگیرد.
یک خطای شایع، انجام تست کاتالاز از کلنیهایی است که روی آگار خوندار رشد کردهاند. گلبولهای قرمز دارای کاتالاز هستند و اگر هنگام برداشتن کلنی، کمی از آگار یا خود گلبولهای قرمز برداشته شود، ممکن است حبابهایی ایجاد شود که به غلط به عنوان نتیجه مثبت تفسیر گردد. برای پیشگیری از این خطا، توصیه میشود تا حد امکان کلنی از محیط بدون خون (مثل آگار مولر–هینتون یا آگار نوترینت) برداشته شود، یا اگر مجبور به استفاده از آگار خون هستیم، ابتدا کلنی را از سطح منتقل و سپس تست را انجام دهیم و از برداشتن ذرات آگار اجتناب کنیم.
برای مشاهده جزئیات کامل روش انجام، خطاهای رایج و کنترل کیفی تست کاتالاز (Catalase test) در افتراق استافیلوکوک از استرپتوکوک، مقاله زیر در هموستیکا را ببینید:
روش انجام و کنترل کیفی تست کاتالاز: راهنمای جامع برای کارشناسان آزمایشگاه
تست کوآگولاز (Coagulase test) برای شناسایی Staphylococcus aureus
پس از تأیید کاتالاز مثبت بودن یک کوکسی گرممثبت و تقویت احتمال استافیلوکوک، گام بعدی معمولاً افتراق استافیلوکوک اورئوس (Staphylococcus aureus) از سایر استافیلوکوکها (که قبلاً به عنوان Coagulase-negative Staphylococci یا CoNS شناخته میشدند) است.
تست کوآگولاز به دو شکل انجام میشود:
- کوآگولاز متصل (آزمایش اسلاید): در این روش، سوسپانسیونی از کلنی باکتری در سرم یا محلول حاوی فیبرینوژن روی لام تهیه میشود. اگر باکتری دارای کوآگولاز متصل باشد، در عرض چند ثانیه تا چند دقیقه، تجمعات و کلوخههای قابلمشاهده ایجاد میشود. این روش سریع است ولی ممکن است بهخصوص در برخی سویهها منفی کاذب بدهد.
- کوآگولاز آزاد (آزمایش لولهای): در این روش، کلنی باکتری در پلاسمای حاوی فیبرینوژن (معمولاً پلاسمای خرگوش) تلقیح و در انکوباتور ۳۷ درجه قرار داده میشود. اگر کوآگولاز آزاد باشد، فیبرینوژن را به فیبرین تبدیل کرده و در عرض چند ساعت تا ۲۴ ساعت، لخته قابللمس و قابلمشاهده در لوله تشکیل میشود. این روش حساستر است و برای تأیید نتایج منفی اسلاید توصیه میشود.
S. aureus تقریباً همیشه کوآگولاز مثبت است و این ویژگی، همراه با سایر تستها، آن را از استافیلوکوکهای کوآگولاز منفی (مانند S. epidermidis و S. saprophyticus) متمایز میکند. این موضوع اهمیت بالینی دارد؛ چرا که S. aureus معمولاً پاتوژن تهاجمیتر و مرتبط با عفونتهای جدیتری است.
برای مطالعه جزئیات کامل روش انجام، تفسیر نتایج و کنترل کیفی تست کوآگولاز (Coagulase test) در افتراق استافیلوکوک از استرپتوکوک، از این مقاله هموستیکا استفاده کنید:
اصول، روش کار، تفسیر نتایج و کنترل کیفی تست کواگولاز: راهنمای جامع برای کارشناسان آزمایشگاه
الگوی همولیز روی آگار خون در افتراق استرپتوکوکها
الگوی همولیز روی آگار خون (Blood agar) در افتراق استرپتوکوکها نقش کلیدی دارد، اما در مورد استافیلوکوکها نیز اطلاعات مفیدی به دست میدهد. بهطور کلی سه نوع همولیز تعریف میشود:
- بتاهمولیز (β-hemolysis): لیز کامل گلبولهای قرمز اطراف کلنی و شفاف شدن محیط. S. pyogenes (گروه A) و S. agalactiae (گروه B) نمونههای بارز بتاهمولیتیک هستند. بسیاری از سویههای S. aureus نیز روی آگار خون، ناحیهای از همولیز کامل را نشان میدهند.
- آلفاهمولیز (α-hemolysis): تجزیه ناقص هموگلوبین و تبدیل آن به متهموگلوبین که به صورت هاله سبز–قهوهای اطراف کلنی دیده میشود. S. pneumoniae و استرپتوکوکهای گروه ویریدانس (Viridans streptococci) عمدتاً آلفاهمولیتیک هستند.
- گاماهمولیز (γ-hemolysis): در واقع عدم همولیز است و تغییر محسوسی در محیط اطراف کلنی دیده نمیشود. برخی استرپتوکوکها و انتروکوکها در این دسته قرار میگیرند.
برای تفسیر صحیح همولیز، باید به ضخامت لایه خون در آگار، سن کلنی، و شرایط انکوباسیون توجه داشت. گاهی همولیز در ابتدا ضعیف است و پس از ۴۸ ساعت انکوباسیون واضحتر میشود. همچنین برخی باکتریها ممکن است بسته به نوع محیط و منشأ سویه، الگوی همولیز متفاوتی نشان دهند. بنابراین، همولیز باید در کنار سایر تستها تفسیر شود نه بهعنوان تنها معیار.
تست PYR و تستهای مقدماتی دیگر در افتراق استرپتوکوکها
در افتراق استرپتوکوکها، بهویژه در تمایز بین S. pyogenes و سایر بتاهمولیتیکها، استفاده از تست PYR (L-pyrrolidonyl-β-naphthylamide) کمککننده است. S. pyogenes و انتروکوکها معمولاً PYR مثبتاند، در حالی که سایر استرپتوکوکهای بتاهمولیتیک PYR منفی هستند. این تست نیز ساده، سریع و قابلاستفاده در آزمایشگاههای روتین است.
برخی آزمایشگاهها هنوز از تست حساسیت به باسیتراسین (Bacitracin) برای افتراق گروه A استفاده میکنند. در این روش، دیسک باسیتراسین با غلظت کم روی آگار خون قرار داده میشود و اگر استرپتوکوک اطراف دیسک هاله عدم رشد نشان دهد، احتمالاً S. pyogenes است. با این حال، به دلیل حساسیت و اختصاصیت محدود، امروزه تست PYR و کیتهای آنتیژن سریع ترجیح داده میشوند.
برای درک بهتر ارتباط نتایج افتراق استافیلوکوک از استرپتوکوک با تست حساسیت آنتیبیوتیکی (آنتیبیوگرام) و دیسک دیفیوژن، این مطلب را مطالعه کنید:
دیسک آنتی بیوگرام: راهنمای جامع تست حساسیت آنتی بیوتیکی
تستهای پیشرفته و مولکولی در افتراق استافیلوکوک از استرپتوکوک
اگرچه بسیاری از جداسازیها و شناساییهای روزمره استافیلوکوک و استرپتوکوک با تکیه بر تستهای سادهای مانند کاتالاز، کوآگولاز، همولیز و چند تست بیوشیمیایی دیگر به نتیجه میرسد، اما در موارد خاص – مانند عفونتهای شدید، بیماران بستری در ICU، مطالعات اپیدمیولوژیک یا آزمایشگاههای مرجع – نیاز به روشهای دقیقتر و پیشرفتهتر وجود دارد.
گروهبندی لنسفیلد (Lancefield grouping) در استرپتوکوکها
استرپتوکوکها بر اساس وجود آنتیژنهای پلیساکاریدی خاص در دیواره سلولی به گروههای مختلفی تقسیم میشوند که به عنوان گروههای لنسفیلد (Lancefield groups) (A، B، C، G و …) شناخته میشوند. S. pyogenes در گروه A، S. agalactiae در گروه B، و برخی استرپتوکوکهای حیوانی در گروههای دیگر قرار میگیرند.
روش کلاسیک، استخراج آنتیژن دیوارهای و استفاده از سرمهای ضدسرمی بود، اما امروزه عمدتاً از کیتهای لاتکس آگلوتیناسیون (Latex agglutination kits) یا تستهای آنتیژن سریع استفاده میشود که به صورت کیت تجاری در دسترساند. تعیین گروه لنسفیلد بهویژه در افتراق بین استرپتوکوکهای بتاهمولیتیک اهمیت دارد؛ زیرا الگوی بیماریزایی و پروفایل مقاومت دارویی گروههای مختلف متفاوت است.
PCR و روشهای مولکولی در شناسایی استافیلوکوک و استرپتوکوک
روشهای مبتنی بر PCR (Polymerase Chain Reaction) امکان شناسایی سریع و دقیق گونهها و حتی ژنهای مقاومت آنتیبیوتیکی را فراهم میکنند. برای مثال، تشخیص ژن mecA یا mecC در استافیلوکوکها برای شناسایی MRSA، یا ژنهای کدکننده توکسینهای خاص، در تصمیمگیری درمانی و کنترل عفونت نقش دارد. در مورد استرپتوکوکها نیز PCR میتواند برای شناسایی S. pneumoniae از سایر استرپتوکوکهای آلفاهمولیتیک، یا تشخیص سریع S. agalactiae در نمونههای واژینال زنان باردار به کار رود.
مزیت مهم PCR، سرعت بالا و حساسیت زیاد آن است، بهخصوص در نمونههایی که کشت آنها دشوار است یا قبل از نمونهگیری آنتیبیوتیک مصرف شده است. با این حال، هزینه نسبتاً بالا، نیاز به تجهیزات و تخصص، و خطر آلودگی و مثبت کاذب از محدودیتهای آن است.
MALDI-TOF MS در شناسایی سریع استافیلوکوک و استرپتوکوک
طیفسنجی جرمی مبتنی بر لیزر (MALDI-TOF MS: Matrix-Assisted Laser Desorption/Ionization Time-of-Flight Mass Spectrometry) در سالهای اخیر انقلابی در شناسایی میکروارگانیسمها ایجاد کرده است. در این روش، بخشی از کلنی باکتری روی یک پلیت ویژه قرار میگیرد، با ماتریکس مخلوط میشود و سپس با لیزر یونیزه میگردد. طیف جرمی حاصل با بانک داده مرجع مقایسه شده و در عرض چند دقیقه هویت باکتری تعیین میشود.
MALDI-TOF قادر است انواع استافیلوکوکها و استرپتوکوکها را با دقت بالا در سطح گونه شناسایی کند. این روش در آزمایشگاههایی که حجم بالای کشت و شناسایی دارند، از نظر زمانی و اقتصادی مقرونبهصرفه است، هرچند هزینه اولیه دستگاه و نیاز به نگهداری و کالیبراسیون منظم باید در نظر گرفته شود.
تستهای آنتیبادی و سرولوژیک در عفونتهای استرپتوکوکی
در برخی موارد، بهخصوص در تشخیص عوارض پسعفونی استرپتوکوک گروه A مانند تب روماتیسمی یا گلومرولونفریت، از تستهای سرولوژیک مانند اندازهگیری تیتر آنتیاسترپتولیزین O (ASO) استفاده میشود. در این شرایط، ممکن است عامل عفونی دیگر در حلق حضور نداشته باشد، اما افزایش تیتر آنتیبادی در سرم بیمار، عفونت اخیر استرپتوکوکی را تأیید میکند.
اگرچه تستهای سرولوژیک مستقیماً در افتراق استافیلوکوک از استرپتوکوک کاربرد ندارند، اما در تأیید نقش استرپتوکوک در بیماریهای خاص کمککنندهاند و تکمیلکننده اطلاعات حاصل از کشت و تستهای بیوشیمیایی هستند.
روشهای کشت و محیطهای انتخابی برای استافیلوکوک و استرپتوکوک
کشت صحیح و انتخاب محیط مناسب، اساس شناسایی دقیق هر باکتری است. برای افتراق استافیلوکوک از استرپتوکوک، انتخاب محیطهایی که ویژگیهای خاص رشد این دو جنس را برجسته کند، بسیار کمککننده است.
مانیتول سالت آگار (Mannitol Salt Agar, MSA) و رشد استافیلوکوکها
MSA یک محیط انتخابی–افتراقی است که بهطور خاص برای استافیلوکوکها طراحی شده است. این محیط حاوی غلظت بالای نمک (معمولاً ۷٫۵٪ NaCl) است که رشد بسیاری از باکتریها را مهار میکند، اما استافیلوکوکها نسبتاً نسبت به این غلظت نمک مقاوماند و به راحتی روی آن رشد میکنند.
علاوه بر خاصیت انتخابی، مانیـتول و شناساگر pH (مانند فنول رد) در محیط وجود دارد. استافیلوکوک اورئوس قادر به تخمیر مانیتول و تولید اسید است؛ در نتیجه pH محیط کاهش یافته و رنگ محیط به زرد تغییر میکند. در مقابل، بسیاری از استافیلوکوکهای کوآگولاز منفی و اکثر باکتریهای دیگر مانیتول را تخمیر نمیکنند و رنگ محیط قرمز یا صورتی باقی میماند. بنابراین، روی MSA نه تنها میتوان رشد استافیلوکوکها را از سایر باکتریها جدا کرد، بلکه میتوان تا حدی S. aureus را نیز از سایر استافیلوکوکها متمایز ساخت.
استرپتوکوکها معمولاً به دلیل حساسیت به غلظت بالای نمک، روی MSA رشد مطلوبی ندارند و این خود بهطور غیرمستقیم در افتراق آنها از استافیلوکوکها کمک میکند، هرچند باید در نظر داشت که تشخیص نهایی بر اساس مجموع یافتهها صورت میگیرد.
آگار خون (Blood Agar) در افتراق همولیز استرپتوکوک و استافیلوکوک
آگار خون، یک محیط غنیشده عمومی است که برای رشد طیف وسیعی از باکتریها از جمله استافیلوکوک و استرپتوکوک استفاده میشود. در این محیط، علاوه بر امکان رشد، میتوان الگوی همولیز را نیز مشاهده و ثبت کرد.
استرپتوکوکها بهویژه در تفسیر الگوی همولیز اهمیت زیادی دارند. همانگونه که گفته شد، S. pyogenes بتاهمولیتیک، S. pneumoniae آلفاهمولیتیک، و برخی استرپتوکوکها و انتروکوکها بدون همولیز (گاما) هستند. مشاهده همولیز در کنار تستهای دیگر مانند حساسیت به اپتوچین (Optochin)، تست حلالیت در صفرا (Bile solubility)، یا گروهبندی لنسفیلد، امکان شناسایی در سطح گونه را فراهم میکند.
در مورد استافیلوکوکها نیز الگوی همولیز میتواند مفید باشد؛ بسیاری از سویههای S. aureus بتاهمولیز واضحی ایجاد میکنند، در حالی که استافیلوکوکهای کوآگولاز منفی غالباً همولیز ندارند یا همولیز بسیار خفیف است. با این حال، وابستگی بیش از حد به همولیز برای تشخیص استافیلوکوکها توصیه نمیشود و باید آن را در کنار سایر تستها در نظر گرفت.
سایر محیطها و شرایط کشت در افتراق استافیلوکوک از استرپتوکوک
در برخی آزمایشگاهها، از محیطهای انتخابی دیگری مانند CHROMagarهای اختصاصی برای شناسایی MRSA یا استرپتوکوک گروه B استفاده میشود. این محیطها حاوی کروموژنهای خاص و در مواردی آنتیبیوتیک انتخابی هستند که کلنیها را به رنگهای متفاوت در میآورند و شناسایی را تسهیل میکنند.
شرایط انکوباسیون نیز مهم است. بسیاری از استرپتوکوکها، از جمله S. pneumoniae، در شرایط CO2 بالا (۵٪) بهتر رشد میکنند. اگر آزمایشگاه فاقد انکوباتور CO2 باشد، میتوان از شمع یا سیستمهای ساده ایجاد CO2 در جارهای انکوباسیون استفاده کرد. در مقابل، استافیلوکوکها معمولاً در انکوباتور معمولی ۳۷ درجه سانتیگراد بدون نیاز به CO2 اضافی بهخوبی رشد میکنند.
در نهایت، باید توجه داشت که کیفیت محیط کشت، تاریخ انقضا، شرایط نگهداری، و روش تلقیح و انکوباسیون همگی بر کیفیت رشد و امکان تفسیر صحیح تأثیر میگذارند.
برای اینکه نتایج کشت و افتراق استافیلوکوک و استرپتوکوک قابل اعتماد باشد، اجرای دقیق کنترل کیفی ضروری است. جزئیات بیشتر را در این مقاله ببینید:
کنترل کیفی میکروب شناسی: اصول، روشها و استانداردهای عملکردی
جنبههای بالینی و اپیدمیولوژیک در افتراق استافیلوکوک از استرپتوکوک و نقش عفونتهای بیمارستانی
از دید بالینی، افتراق استافیلوکوک از استرپتوکوک تنها یک تمرین آزمایشگاهی نیست، بلکه مستقیماً بر انتخاب درمان، پیشآگهی بیمار و اقدامات کنترل عفونت تأثیر میگذارد.
استافیلوکوکها: عفونتهای پوستی، MRSA و عفونتهای بیمارستانی
استافیلوکوکها در حالت طبیعی به عنوان فلور طبیعی پوست و مخاط (بهویژه بینی و حلق) حضور دارند. S. aureus به صورت کلونیزاسیون بدون علامت در بخشی از جمعیت (حدود ۲۰–۳۰ درصد) در ناحیه قدامی بینی یافت میشود. این کلونیزاسیون، در عین حال که ممکن است بدون علامت باشد، یک منبع بالقوه برای عفونتهای فرصتطلب است؛ به خصوص در بیماران با زخم جراحی، دیابت، نقص ایمنی یا حضور ابزارهای پروتزی و کاتترها.
از مهمترین عفونتهای ناشی از S. aureus میتوان به فولیکولیت، فورنکل، کاربونکل، آبسههای پوستی، سلولیت، عفونت زخمهای جراحی، استئومیلیت، اندوکاردیت عفونی، پنومونی بیمارستانی، سپسیس و سندرم شوک توکسیک اشاره کرد. برخی سویهها تولید توکسینهای خاصی مانند توکسین لوسیدرمن نکروزان یا توکسینهای سوپرانتیژن میکنند که شدت بیماری را افزایش میدهند.
چالش بزرگ در حوزه استافیلوکوکها، ظهور و گسترش MRSA (Methicillin-Resistant Staphylococcus aureus) است. در MRSA، حضور ژن mecA (یا در برخی موارد mecC) باعث تولید پروتئین PBP2a میشود که به بتالاکتامها (بهجز چند مورد خاص مانند سفالوسپورینهای نسل جدید) حساسیت ندارد. این موضوع، دامنه انتخاب آنتیبیوتیکی را محدود و نیاز به استفاده از داروهای گرانتر و پیچیدهتر مانند وانکومایسین، لینهزولید یا دپتومایسین را ایجاد میکند. در محیط بیمارستانی، MRSA از عوامل مهم عفونتهای اکتسابی و عفونتهای مرتبط با مراقبتهای سلامت (Healthcare-associated infections) است و کنترل آن نیازمند برنامههای دقیق کنترل عفونت، غربالگری، ایزولاسیون بیماران و سیاستهای آنتیبیوتیکی منطقی است.
استرپتوکوکها: فارنژیت، تب روماتیسمی، سپسیس نوزادی و پنومونی
استرپتوکوکها طیف وسیعی از بیماریها را در جوامع و بیمارستانها ایجاد میکنند. S. pyogenes (گروه A) یکی از شایعترین عوامل فارنژیت باکتریال در کودکان است. این باکتری علاوه بر بیماریهای حاد مانند فارنژیت، تب مخملک، سلولیت و امپیما، در صورت عدم درمان مناسب میتواند منجر به عوارض پسعفونی مهمی مانند تب روماتیسمی و گلومرولونفریت حاد شود که پایه ایمونولوژیک دارند. تشخیص بهموقع و درمان کامل فارنژیت استرپتوکوکی با پنیسیلین یا سایر آنتیبیوتیکهای مناسب، نقش مهمی در پیشگیری از این عوارض دارد.
S. agalactiae (گروه B) از پاتوژنهای مهم در سپسیس و مننژیت نوزادان است. زنان بارداری که بهطور بیعلامت در دستگاه تناسلی تحتانی حامل این باکتری هستند، میتوانند در حین زایمان آن را به نوزاد منتقل کنند. به همین دلیل، در بسیاری از کشورها غربالگری زنان باردار در اواخر بارداری برای استرپتوکوک گروه B و در صورت لزوم، پروفیلاکسی آنتیبیوتیکی داخل وریدی حین زایمان توصیه میشود.
S. pneumoniae عامل مهمی برای پنومونی اکتسابی از جامعه، اوتیت مدیا، سینوزیت، مننژیت و سپسیس است و بهویژه در کودکان، سالمندان و افراد دچار نقص طحال یا نقص سیستم ایمنی اهمیت دارد. مقاومت به پنیسیلین و سایر آنتیبیوتیکها در پنوموکوک نیز یک معضل رو به افزایش است و تفسیر نتایج تستهای حساسیت بر اساس استانداردهای بهروز (CLSI یا EUCAST) اهمیت زیادی دارد.
استرپتوکوکهای گروه ویریدانس و انتروکوکها هم در برخی شرایط، بهخصوص در بیماران دچار نقص ایمنی یا با آسیبهای ساختاری قلب، میتوانند باعث اندوکاردیت تحتحاد شوند.
از منظر اپیدمیولوژیک، دانستن اینکه باکتری جداسازیشده استافیلوکوک است یا استرپتوکوک، در تصمیمگیری برای گزارش به واحد کنترل عفونت، اجرای اقدامات ایزولاسیون، بررسی حاملان، و تحلیل الگوهای شیوع در بخشهای مختلف بیمارستان، نقش اساسی دارد.
برای ارتباط بهتر نتایج افتراق استافیلوکوک و استرپتوکوک با انتخاب آنتیبیوتیک مناسب بر اساس تست حساسیت (AST)، توصیه میشود این مطلب را بخوانید:
دیسک آنتی بیوگرام: راهنمای جامع تست حساسیت آنتی بیوتیکی
چالشها و خطاهای رایج در افتراق استافیلوکوک از استرپتوکوک
هیچ روش آزمایشگاهیای عاری از خطا نیست و شناخت منابع خطا، بخش مهمی از مهارت حرفهای یک کارشناس آزمایشگاه محسوب میشود. در افتراق استافیلوکوک از استرپتوکوک، برخی خطاها و چالشهای شایع عبارتاند از:
تفسیر نادرست تست کاتالاز
همانطور که ذکر شد، انجام تست کاتالاز از کلنی روی آگار خون میتواند به مثبت کاذب منجر شود، زیرا گلبولهای قرمز خود دارای کاتالاز هستند. گاهی کارشناس بدون توجه به این نکته، حبابهای ناشی از کاتالاز RBC را به حساب کاتالاز باکتری میگذارد و یک استرپتوکوک را به اشتباه استافیلوکوک گزارش میکند. استفاده از محیط بدون خون، برداشتن کلنی بدون آگار، و وجود کنترل مثبت و منفی در کنار تست، راهکارهای مهم برای جلوگیری از این خطاست.
بیتوجهی به سن کلنی و شرایط کشت
اگر کلنیها بیش از حد قدیمی باشند (مثلاً چند روز در انکوباتور یا یخچال مانده باشند)، ممکن است ویژگیهای مورفولوژیک تغییر کنند، همولیز کمتر دیده شود، یا تستهای بیوشیمیایی نتایج غیرقابلاعتماد بدهند. در چنین شرایطی، بهتر است از کلنی تازهکشت دادهشده برای تستهای تأییدی استفاده شود. همچنین انکوباسیون در دماهای نامناسب یا محیطهای فاقد کیفیت استاندارد، میتواند الگوی رشد را مختل کند.
عدم استفاده از الگوریتم چندمرحلهای
یکی از خطاهای رایج، اتکا به یک تست منفرد بدون در نظر گرفتن سایر یافتهها است. برای مثال، ممکن است یک کوکسی گرممثبت، کاتالاز مثبت و روی MSA رشد کننده و مانیتول را تخمیرکننده باشد، اما برای اطمینان از S. aureus بودن آن، انجام تست کوآگولاز و در صورت لزوم، روشهای تکمیلی ضروری است. یا در مورد استرپتوکوکها، تکیه تنها بر همولیز بدون انجام تستهای اضافی مانند گروهبندی لنسفیلد، PYR، یا حساسیت به اپتوچین میتواند به شناسایی نادرست منجر شود.
آلودگی نمونه و کشتهای مختلط
در نمونههایی مانند سواب حلق، زخمهای باز یا ترشحات تنفسی، حضور فلور طبیعی و باکتریهای متعدد شایع است. اگر نمونهگیری بهدرستی انجام نشود یا محیط انتقال و شرایط نگهداری مناسب نباشد، احتمال آلودگی و رشد باکتریهای غیرمرتبط افزایش مییابد. در این شرایط، افتراق بین باکتری پاتوژن اصلی و فلور همراه نیازمند دقت، تجربه و گاهاً اطلاعات بالینی تکمیلی است. عدم ارتباط مناسب بین بخش میکروبیولوژی و تیم بالینی نیز میتواند به تفسیر غلط و گزارش نادرست منجر شود.
تفسیر نادرست همولیز
گاهی هاله همولیز خیلی ظریف است و در نور نامناسب یا پس از مدت انکوباسیون کوتاه ممکن است نادیده گرفته شود. از طرف دیگر، تغییرات جزئی رنگ محیط ممکن است به اشتباه بهعنوان همولیز تفسیر شود. استفاده از نور مناسب، بررسی از زیر، و در صورت نیاز، انکوباسیون تا ۴۸ ساعت میتواند به تفسیر دقیقتر کمک کند. همچنین باید به تفاوت بین بتاهمولیز واقعی و شبههمولیز (در برخی باسیلهای گرممنفی) توجه داشت.
نادیده گرفتن استانداردها و کنترل کیفی
استانداردهای بینالمللی مانند CLSI (Clinical and Laboratory Standards Institute) و EUCAST (European Committee on Antimicrobial Susceptibility Testing) نه تنها برای تفسیر نتایج تستهای حساسیت آنتیبیوتیکی، بلکه برای بسیاری از جنبههای عملکرد آزمایشگاه، شامل تهیه محیطها، کالیبراسیون دستگاهها و کیفیت کیتهای تشخیصی، توصیههایی ارائه میکنند. نادیده گرفتن این استانداردها، استفاده از معرفها و محیطهای تاریخگذشته، یا بیتوجهی به برنامههای کنترل کیفی داخلی و خارجی، احتمال بروز خطا را افزایش میدهد.
کمبود آموزش و بهروزرسانی دانش
میکروبیولوژی یک حوزه پویاست و روشهای جدید، الگوهای جدید مقاومت، و دستورالعملهای تازه بهطور مداوم منتشر میشوند. اگر کارشناسان آزمایشگاه بهروز نگه داشته نشوند، ممکن است همچنان به روشهای قدیمی با حساسیت و اختصاصیت پایین متکی بمانند. برگزاری کارگاهها، دورههای بازآموزی و مطالعه مداوم منابع معتبر برای حفظ کیفیت تشخیص ضروری است.
برای کاهش خطاهای آزمایشگاهی در افتراق استافیلوکوک از استرپتوکوک، آشنایی با اصول کنترل کیفی و خطاهای رایج ضروری است:
کنترل کیفی میکروب شناسی: اصول، روشها و استانداردهای عملکردی
جدولهای افتراقی آزمایشگاهی و بالینی استافیلوکوک و استرپتوکوک
جدول مقایسهای افتراق استافیلوکوک و استرپتوکوک
| ویژگی | استافیلوکوکها (Staphylococcus) | استرپتوکوکها (Streptococcus) |
|---|---|---|
| رنگآمیزی گرم | کوکسی گرممثبت | کوکسی گرممثبت |
| آرایش سلولی | خوشهای (شبیه خوشه انگور) | زنجیرهای یا دیپلوکوک (گاهی لانستشکل در S. pneumoniae) |
| محل طبیعی کلونیزاسیون | پوست، مخاط بینی و حلق | مخاط حلق، دستگاه تنفس فوقانی، دستگاه تناسلی، روده |
| تست کاتالاز | مثبت | منفی |
| تست کوآگولاز | S. aureus اغلب مثبت؛ بسیاری از استافیلوکوکهای دیگر منفی | همگی کوآگولاز منفی |
| رشد روی مانیتول سالت آگار (MSA) | رشد خوب؛ S. aureus مانیتول را تخمیر میکند (زرد شدن محیط) | معمولاً رشد ضعیف یا عدم رشد به علت غلظت بالای نمک |
| همولیز روی آگار خون | متغیر؛ بسیاری از سویههای S. aureus بتاهمولیتیک | آلفا، بتا یا گاما همولیتیک؛ الگوی همولیز برای افتراق گونهها بسیار مهم است |
| گروهبندی لنسفیلد | معمولاً استفاده نمیشود | بر اساس آنتیژن دیواره (گروههای A، B، C، G و …) |
| PYR | معمولاً منفی | مثبت در S. pyogenes و Enterococcus ها؛ منفی در بسیاری از استرپتوکوکهای دیگر |
| محیطهای انتخابی رایج | MSA، کرومآگارهای اختصاصی MRSA | آگار خون، محیطهای اختصاصی برای گروه B، محیطهای غنی در CO₂ |
| مقاومت آنتیبیوتیکی شاخص | مشکل عمده: MRSA (مقاوم به متیسیلین و اغلب بتالاکتامها)، گاهی مقاومت به ماکرولید، فلوروکینولون و… | در گروه A معمولاً هنوز حساس به پنیسیلین؛ اما مقاومت به ماکرولیدها در حال افزایش؛ در S. pneumoniae مقاومت به پنیسیلین و سفالوسپورینها رو به افزایش |
| عفونتهای شایع | عفونتهای پوستی و بافت نرم، آبسه، عفونت زخم جراحی، اندوکاردیت، پنومونی بیمارستانی | فارنژیت، تب مخملک، سلولیت، پنومونی اکتسابی از جامعه، مننژیت، سپسیس نوزادی |
| نقش در عفونتهای بیمارستانی | بسیار مهم (بهویژه MRSA، عفونت زخم، کاتتر و پروتز) | مهم ولی بیشتر در زمینه پنومونی، سپسیس و مننژیت (مثلاً S. pneumoniae, S. agalactiae) |
| اهمیت اپیدمیولوژیک | ناقلین بینی S. aureus، انتشار MRSA در جامعه و بیمارستان | شیوع جهانی S. pyogenes، گروه B در بارداری و نوزادان، پنوموکوک در کودکان و سالمندان |
| روشهای تشخیصی پیشرفته | MALDI-TOF، PCR برای ژن mecA/mecC، تعیین توکسینها | MALDI-TOF، PCR برای شناسایی گروه و گونه، تستهای آنتیژن سریع (گروه A و B) |
جدول افتراقی ویژگیهای آزمایشگاهی و بالینی استافیلوکوکها و استرپتوکوکها
| ویژگی | استافیلوکوکها (Staphylococcus) | استرپتوکوکها (Steptococcus) |
|---|---|---|
| شکل و آرایش میکروسکوپی (Gram) | کوکسی گرممثبت به صورت خوشهای (cluster) شبیه خوشه انگور | کوکسی گرممثبت به صورت زنجیرهای یا دیپلوکوک (بهخصوص در S. pneumoniae به شکل لانست) |
| تست کاتالاز | مثبت (تولید حباب با H₂O₂) | منفی |
| تست کوآگولاز | در S. aureus مثبت؛ در استافیلوکوکهای کوآگولاز منفی (CoNS) منفی | همگی کوآگولاز منفی |
| رشد روی مانیتول سالت آگار (MSA) | رشد خوب؛ S. aureus معمولاً مانیتول را تخمیر کرده و محیط را زرد میکند | معمولاً رشد ضعیف یا عدم رشد به دلیل حساسیت به نمک بالا |
| الگوی همولیز روی آگار خون | متغیر؛ S. aureus غالباً بتاهمولیتیک؛ CoNS معمولاً بدون همولیز یا همولیز خفیف | بتاهمولیز (S. pyogenes، S. agalactiae)، آلفاهمولیز (S. pneumoniae، ویریدانس)، یا بدون همولیز (برخی استرپتوکوکها و انتروکوکها) |
| گروهبندی لنسفیلد | ندارد | بر اساس آنتیژن دیواره (گروه A، B، C، G و … ) قابل گروهبندی |
| تست PYR | معمولاً منفی در استافیلوکوکها | مثبت در S. pyogenes و انتروکوکها؛ منفی در بسیاری از استرپتوکوکهای دیگر |
| محل طبیعی کلونیزاسیون | پوست، سوراخهای بینی، نواحی مرطوب بدن (زیربغل، کشاله ران) | حلق و نازوفارنکس (گروه A، پنوموکوک، ویریدانس)، دستگاه تناسلی تحتانی (گروه B)، دستگاه گوارش (برخی گونهها و انتروکوکها) |
| عفونتهای شایع | عفونتهای پوستی و بافت نرم (فورونکل، کاربونکل، آبسه)، عفونت زخم جراحی، استئومیلیت، اندوکاردیت حاد، پنومونی بیمارستانی، سپسیس، سندرم شوک توکسیک | فارنژیت چرکی، تب مخملک، سلولیت و اریزیپلاس، تب روماتیسمی و گلومرولونفریت پساسترپتوکوکی (گروه A)، سپسیس و مننژیت نوزادی (گروه B)، پنومونی، اوتیت مدیا، مننژیت (S. pneumoniae)، اندوکاردیت تحتحاد (ویریدانس) |
| مقاومت آنتیبیوتیکی شاخص | مشکل عمده: MRSA (مقاوم به متیسیلین و اغلب بتالاکتامها)، گاهی مقاومت به ماکرولید، فلوروکینولون، و لینهزولید در برخی سویهها | در گروه A معمولاً هنوز حساس به پنیسیلین؛ اما مقاومت به ماکرولیدها در حال افزایش؛ در S. pneumoniae مقاومت به پنیسیلین و سفالوسپورینها رو به افزایش |
| اهمیت در عفونتهای بیمارستانی (Nosocomial) | بسیار بالا؛ بهویژه MRSA در ICU، جراحی، ارتوپدی، دیالیز، و عفونتهای مرتبط با کاتتر و پروتز | اهمیت در جامعه و بیمارستان؛ S. pneumoniae در پنومونی اکتسابی از جامعه؛ استرپتوکوک گروه B در واحدهای نوزادان؛ برخی استرپتوکوکها و انتروکوکها در اندوکاردیت و عفونتهای مرتبط با مراقبتهای سلامت |
| پیامدهای ایمونولوژیک/پسعفونی کلاسیک | کمتر؛ بیشتر عوارض ناشی از خود عفونت یا توکسینها (مثلاً سندرم پوست سوخته، شوک توکسیک) | تب روماتیسمی، گلومرولونفریت حاد پساسترپتوکوکی (بهویژه پس از عفونت با S. pyogenes) |
| نقش در فلور طبیعی و پاتوژن فرصتطلب | بخشی از فلور طبیعی پوست؛ با اختلال سد پوستی یا حضور جسم خارجی به پاتوژن فرصتطلب مهم تبدیل میشود | بخشی از فلور طبیعی حلق و دهان و روده؛ در شرایط خاص (نقص ایمنی، بیماری زمینهای، پروتز قلبی) به پاتوژن فرصتطلب تبدیل میشوند |
| الگوی انتشار و اپیدمیولوژی | انتشار از طریق تماس مستقیم پوست به پوست، وسایل آلوده، محیط بیمارستانی؛ حاملان بینی منبع مهم انتشار S. aureus و MRSA هستند | انتشار قطرات تنفسی (S. pyogenes، S. pneumoniae)، تماس نزدیک، انتقال عمودی از مادر به نوزاد (گروه B)، و گاهی انتقال از فلور طبیعی به خون در شرایط تهاجمی |
نتیجهگیری: الگوریتم عملی برای افتراق استافیلوکوک از استرپتوکوک
افتراق استافیلوکوک از استرپتوکوک، فراتر از یک تمرین ساده آزمایشگاهی، یک فرایند چندمرحلهای و سیستماتیک است که از مشاهده میکروسکوپی آغاز شده، با تستهای بیوشیمیایی اولیه مانند کاتالاز و کوآگولاز ادامه مییابد، و در صورت نیاز به استفاده از روشهای پیشرفته مانند گروهبندی لنسفیلد، PCR و MALDI-TOF میرسد.
کارشناس آزمایشگاه باید بداند که هیچ تستی به تنهایی قطعی نیست و همیشه باید ترکیبی از شواهد را در نظر بگیرد:
- آرایش سلولی در رنگآمیزی گرم (خوشهای در استافیلوکوک، زنجیرهای/دیپلو در استرپتوکوک)،
- الگوی رشد و همولیز روی آگار خون،
- رشد و تخمیر مانیتول روی MSA،
- کاتالاز مثبت یا منفی بودن،
- کوآگولاز مثبت یا منفی بودن در استافیلوکوکها،
- گروهبندی لنسفیلد و تستهای تکمیلی مانند PYR در استرپتوکوکها.
اهمیت بالینی این افتراق در انتخاب صحیح آنتیبیوتیک، پیشگیری از عوارض جدی (مثل تب روماتیسمی، اندوکاردیت عفونی، سپسیس و عفونتهای بیمارستانی) و اجرای استراتژیهای کنترل عفونت در سطح بیمارستان و جامعه آشکار است.
در نهایت، رعایت استانداردهای بینالمللی مانند CLSI و EUCAST، اجرای دقیق برنامههای کنترل کیفی، بهروزرسانی مستمر دانش و مهارتهای عملی، و ارتباط نزدیک با تیم بالینی، تضمینکننده آن است که گزارش آزمایشگاه میکروبیولوژی، ابزاری مطمئن و مؤثر در دست پزشک برای تصمیمگیری درمانی باشد.
سوالات رایج درباره افتراق استافیلوکوک از استرپتوکوک (FAQ)
1. مهمترین تست اولیه برای افتراق استافیلوکوک از استرپتوکوک چیست؟
مهمترین تست اولیه، تست کاتالاز است. استافیلوکوکها کاتالاز مثبت و استرپتوکوکها کاتالاز منفی هستند. بنابراین هر کوکسی گرممثبت کاتالاز مثبت در قدم اول بیشتر به نفع استافیلوکوک و هر کوکسی گرممثبت کاتالاز منفی بیشتر به نفع استرپتوکوک یا انتروکوک است.
2. آیا فقط با رنگآمیزی گرم میتوان افتراق استافیلوکوک از استرپتوکوک را انجام داد؟
خیر. هر دو جنس، کوکسیهای گرممثبت هستند و رنگآمیزی گرم به تنهایی کافی نیست. اگرچه آرایش خوشهای بیشتر به نفع استافیلوکوک و آرایش زنجیرهای یا دیپلوکوک به نفع استرپتوکوک است، اما برای تأیید حتماً باید از تستهای بیوشیمیایی مانند کاتالاز و کوآگولاز و در صورت نیاز تستهای تکمیلی استفاده شود.
3. نقش تست کوآگولاز در افتراق استافیلوکوکها چیست؟
تست کوآگولاز برای افتراق Staphylococcus aureus (کوآگولاز مثبت) از سایر استافیلوکوکهای کوآگولاز منفی (CoNS) استفاده میشود. چون S. aureus معمولاً پاتوژن تهاجمیتر است، شناسایی دقیق آن برای مدیریت عفونت و کنترل عفونتهای بیمارستانی اهمیت زیادی دارد.
4. عفونتهای بیمارستانی مرتبط با استافیلوکوک و استرپتوکوک چه تفاوتی دارند؟
استافیلوکوک، بهویژه MRSA، بیشتر با عفونت زخمهای جراحی، عفونتهای مرتبط با کاتتر، پروتز، دیالیز و ICU مرتبط است. استرپتوکوکها هم میتوانند در عفونتهای بیمارستانی نقش داشته باشند، اما بیشتر در زمینه پنومونی، سپسیس، مننژیت (مثلاً S. pneumoniae) و سپسیس نوزادی (S. agalactiae) مطرح هستند.
5. آیا میتوان فقط بر اساس الگوی همولیز روی آگار خون، گونه استرپتوکوک را مشخص کرد؟
الگوی همولیز (آلفا، بتا، گاما) کمک بسیار مهمی در طبقهبندی استرپتوکوکهاست، ولی بهتنهایی برای شناسایی گونه کافی نیست. برای مثال S. pyogenes و S. agalactiae هر دو بتاهمولیتیک هستند، اما برای افتراق آنها باید از تستهایی مانند گروهبندی لنسفیلد، PYR و سایر تستهای بیوشیمیایی استفاده شود.
6. در چه شرایطی استفاده از PCR یا MALDI-TOF در افتراق استافیلوکوک از استرپتوکوک توصیه میشود؟
در عفونتهای شدید (مثل سپسیس، مننژیت)، بیماران ICU، یا مواردی که نتایج روشهای کلاسیک مبهم است، استفاده از PCR برای شناسایی گونه و ژنهای مقاومت (مثل mecA در MRSA) و استفاده از MALDI-TOF MS برای شناسایی سریع در سطح گونه، میتواند بسیار کمککننده باشد. در آزمایشگاههای مرجع و مراکز آموزشی بزرگ، این روشها بهصورت روتینتر به کار میروند.
7. مهمترین خطاهای شایع در افتراق استافیلوکوک از استرپتوکوک کداماند؟
از مهمترین خطاها میتوان به استفاده از کلنی روی آگار خون برای تست کاتالاز (مثبت کاذب)، تفسیر نادرست الگوی همولیز، اتکا به یک تست منفرد بدون در نظر گرفتن سایر شواهد، استفاده از کلنیهای قدیمی، آلودگی نمونه و بیتوجهی به استانداردهای کنترل کیفی اشاره کرد.
8. افتراق استافیلوکوک از استرپتوکوک چه تاثیری بر انتخاب آنتیبیوتیک دارد؟
استافیلوکوکها، بهویژه MRSA، الگوی مقاومت بسیار متفاوتی نسبت به استرپتوکوکها دارند. مثلاً برای MRSA معمولاً از بتالاکتامها استفاده نمیشود و داروهایی مثل وانکومایسین یا لینهزولید مطرحاند، در حالی که S. pyogenes هنوز به پنیسیلین بسیار حساس است. بنابراین افتراق صحیح، پایه انتخاب درمان منطقی و جلوگیری از مقاومت دارویی است.
9. در گسترش مستقیم از خون یا مایع مغزی–نخاعی، آیا میتوان بهطور قطعی استافیلوکوک یا استرپتوکوک را مشخص کرد؟
در گسترش مستقیم، مشاهده کوکسی گرممثبت میتواند سرنخ مهمی باشد، اما به دلیل اختلاط با سلولهای التهابی و سایر عوامل، تشخیص قطعی جنس معمولاً ممکن نیست. با این حال، مشاهده آرایش خوشهای به نفع استافیلوکوک و آرایش زنجیرهای یا دیپلوکوک به نفع استرپتوکوک است، ولی برای تأیید به کشت و تستهای تکمیلی نیاز است.
10. برای کاهش خطا و ارتقای کیفیت در افتراق استافیلوکوک از استرپتوکوک چه اقداماتی توصیه میشود؟
اجرای برنامههای کنترل کیفی داخلی و خارجی، استفاده از کنترل مثبت و منفی در تستهای کلیدی (مثل کاتالاز و کوآگولاز)، بهروزرسانی دانش کارشناسان بر اساس آخرین استانداردهای CLSI و EUCAST، رعایت دقیق شرایط کشت و انکوباسیون، و ارتباط مستمر با تیم بالینی برای تفسیر نتایج در بستر بالینی، همگی در کاهش خطا و ارتقای کیفیت مؤثر هستند.
برای یادگیری قدمبهقدم و عملی تستهایی که در افتراق استافیلوکوک از استرپتوکوک استفاده میشوند (مثل گرام، کاتالاز، کوآگولاز، آنتیبیوگرام)، پیشنهاد میکنیم مجموعه مقالات تخصصی هموستیکا را در بخش میکروبیولوژی مرور کنید.
منابع معتبر برای مطالعه بیشتر
- Carroll KC, Hobden JA, Miller S, et al. Bailey & Scott’s Diagnostic Microbiology. Latest Edition.
- Murray PR, Rosenthal KS, Pfaller MA. Medical Microbiology. Elsevier.
- Koneman EW, Allen SD, Janda WM, et al. Color Atlas and Textbook of Diagnostic Microbiology.
- Jorgensen JH, Pfaller MA, Carroll KC, et al. Manual of Clinical Microbiology. ASM Press.
- Clinical and Laboratory Standards Institute (CLSI) – Performance Standards for Antimicrobial Susceptibility Testing.
- EUCAST (European Committee on Antimicrobial Susceptibility Testing) – Breakpoint tables for interpretation of MICs and zone diameters.
- Mandell GL, Bennett JE, Dolin R. Mandell, Douglas, and Bennett’s Principles and Practice of Infectious Diseases.
- Brooks GF, Carroll KC, Butel JS, Morse SA. Jawetz, Melnick, & Adelberg’s Medical Microbiology.
- PubMed – مقالات مروری و پژوهشی مرتبط با MRSA، Streptococcus pyogenes، Streptococcus agalactiae، و Streptococcus pneumoniae.
- Centers for Disease Control and Prevention (CDC) – اطلاعات اپیدمیولوژیک و راهنماهای بالینی مربوط به عفونتهای استافیلوکوکی و استرپتوکوکی.